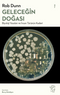

Sepetinde ürün bulunmamaktadır.
- Kitap
- Dergi
- Edebiyat Dergileri
- Tüm Dergiler
- Çocuk Dergileri
- Kültür ve Sanat Dergileri
- Tarih Dergileri
- Bilim Dergileri
- Edebiyat Dergileri
- Hobi & Oyuncak
- Oyun ve Oyuncak
- Puzzle ve Yapboz
- King of Puzzle Ahşap Puzzle
- Oyundan Daha Fazlası
- Montessori Oyuncakları
- Oyun ve Oyuncak
- Kırtasiye
- Defterler
- Kitap Aksesuarları
- Diğer Ürünler
- Bookinzi Kültür ve Sanat Ürünleri
- Kitap Hediye Kartları
- Okul Alışverişi
- Defterler
- Kırkambar
- Temalı ve Lisanslı Ürünler
- Diğer Ürünler
- Bookinzi Kültür ve Sanat Ürünleri
- Miyuki Takılar
- Temalı ve Lisanslı Ürünler
- Tüm Kategoriler




 Değişen Yaşam & İnsanlar Dünyadaki Yaşamı Nasıl Değiştiriyor
Değişen Yaşam & İnsanlar Dünyadaki Yaşamı Nasıl Değiştiriyor
Geleceğin Doğası: Biyoloji Yasaları ve İnsan Türünün Kaderi
Geleceğin Doğası: Biyoloji Yasaları ve İnsan Türünün Kaderi
 Bedenin Sırları & Hayatımızı Değiştirecek Yeni Bir İnsan Biyolojisi
Bedenin Sırları & Hayatımızı Değiştirecek Yeni Bir İnsan Biyolojisi
 Yaşamın Kodu
Yaşamın Kodu
 Gülüşü Tıpkı Annesi & Kalıtımın Gücü, Zayıflığı ve Potansiyeli
Gülüşü Tıpkı Annesi & Kalıtımın Gücü, Zayıflığı ve Potansiyeli





















